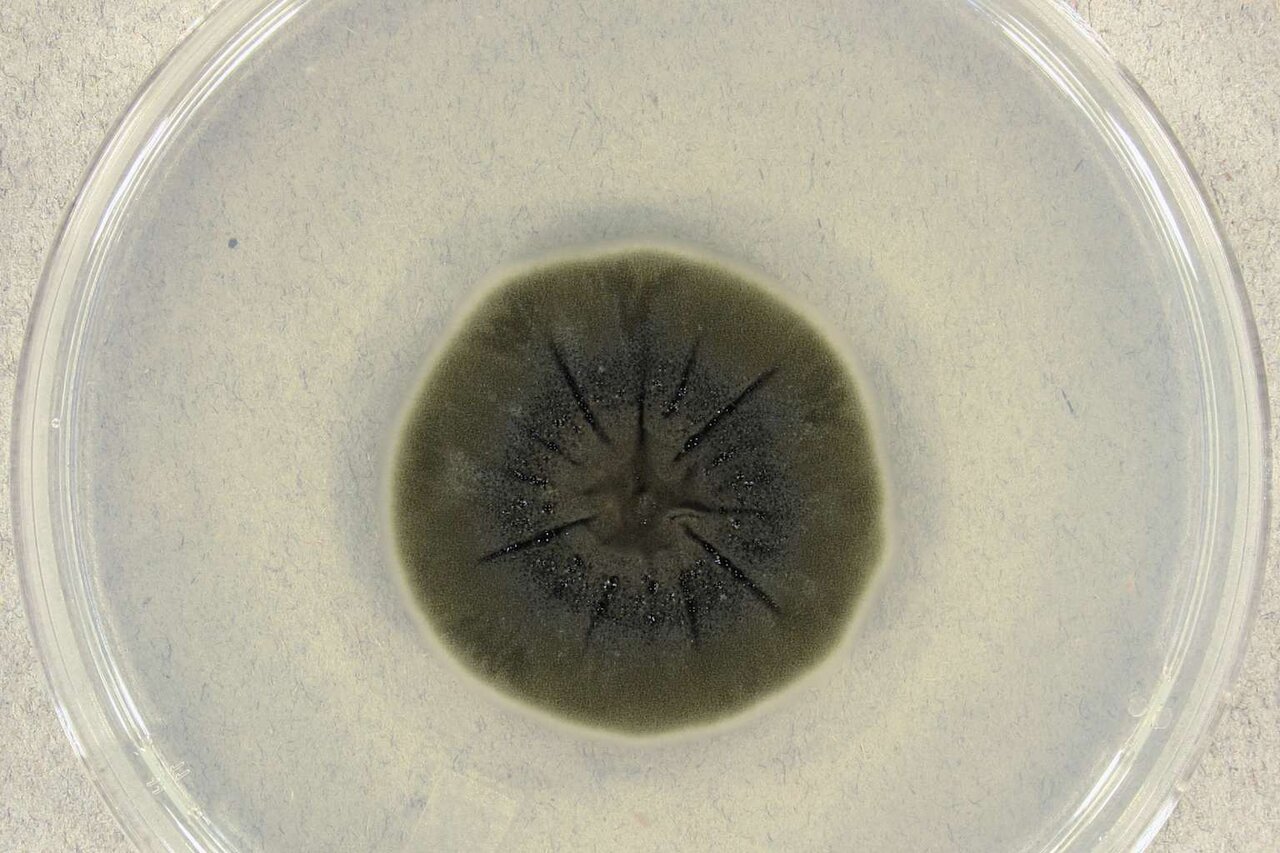
قارچهایی که در تشعشعات چرنوبیل رشد میکنند!

قارچهایی که در تشعشعات چرنوبیل رشد میکنند!
انفجار رآکتور شماره ۴ نیروگاه هستهای چرنوبیل نزدیک پریپیات در اوکراین در ۲۶ آوریل ۱۹۸۶ همچنان بدترین فاجعه هستهای در تاریخ بشر است. این فاجعه یک منطقه ممنوعهی ۳۰ کیلومتری بجای گذاشت.

به گزارش شرق ؛ پس از فاجعه چرنوبیل، دانشمندان تکههایی از رویشهای سیاه را روی دیوارههای رآکتور شماره ۴ مشاهده کردند؛ قارچهایی که با کمال تعجب، به نظر میرسد جایی که تشعشعات بیشتر است، رشد میکنند.
فاجعه چرنوبیل یک منطقه ممنوعهی ۳۰ کیلومتری بجای گذاشت؛ یک منظره متروکه که دههها پس از حادثه، هنوز سطوح بالای تشعشع در آن باقی مانده و سکونت انسان در آن ممنوع شده است.
با این حال، در این منطقه، دانشمندان یک بازمانده بعید را کشف کردهاند: یک قارچ سیاه انعطافپذیر به نام کلادوسپوریوم اسفاروسپرموم (Cladosporium sphaerospermum). پس از فاجعه چرنوبیل، دانشمندان تکههایی از رویشهای سیاه را روی دیوارههای رآکتور شماره ۴ مشاهده کردند؛ قارچهایی که به نظر میرسید جایی که تشعشعات بیشتر بود، رشد کرده بودند.
این قارچ با سطحی از تشعشعات سازگار شده که برای بیشتر اشکال حیات کشنده است. جالبتر اینکه توانایی آن در «تغذیه» از این تشعشع و استفاده از آن به عنوان منبع انرژی، شبیه نحوه استفاده گیاهان از نور خورشید برای فتوسنتز است.
تحقیقات بیشتر نشان داد C. sphaerospermum و برخی دیگر از گونههای قارچ سیاه مانند Wangiella dermatitis و Cryptococcus neoformans ملانین دارند، رنگدانهی مسئول رنگ پوست انسان. با این حال، در این قارچها، ملانین هدف متفاوتی دارد: تابش را جذب و سپس به انرژی قابلاستفاده تبدیل میکند تا در مناطق در معرض رادیواکتیو شدید رشد کند.
این یک سازگاری جالبتوجه است که نشان میدهد شکوفایی حیات چگونه در برخی از خصمانهترین مکانهای این سیاره ممکن میشود.
چگونه تشعشع به منبع انرژی قارچ تبدیل میشود؟
Cladosporium sphaerospermum متعلق به گروهی از قارچهاست که به آنها قارچهای رادیوتروفیک میگویند. ارگانیسمهای رادیوتروفیک میتوانند تشعشعات یونی را برای هدایت فرآیندهای متابولیک جذب کرده و از آنها استفاده کنند.
در مورد C. sphaerospermum، محتوای بالای ملانین به آن اجازه میدهد تشعشع را جذب کند، شبیه نحوه جذب نور خورشید توسط گیاهان از طریق کلروفیل.
این فرآیند شبیه فتوسنتز نیست، اما هدف قابلقیاسی را دنبال میکند و انرژی محیط را برای حفظ رشد تبدیل میکند. این پدیده که رادیوسنتز نام دارد، راههای جالبی را در تحقیقات بیوشیمی و تشعشع گشوده است.
ملانین که در بسیاری از موجودات زنده یافت میشود، یک سپر طبیعی در برابر اشعه ماوراء بنفش است. با این حال، ملانین در C. sphaerospermum، چیزی بیش از سپر است: با تبدیل تابش گاما به انرژی شیمیایی، تولید انرژی را آسان میکند.
مقالهای که سال ۲۰۰۷ در مجله PLOS ONE منتشر شد، این مکانیسم تولید انرژی غیرعادی را تأیید کرد و نشان داد رشد قارچهایی مانند C. sphaerospermum در محیطهایی با تشعشع بالا سریعتر از رشد آنهاست که در شرایط غیر رادیواکتیو رشد میکنند. این کشف درک دانشمندان از استراتژیهای بقاء اِکستِرِموفیلها (ارگانیسمهایی که میتوانند شرایط سخت محیطی را تاب بیاورند) را تغییر داده است.
قارچهای رادیوتروفیک ممکن است متحد ما در مبارزه با تشعشعات باشند
کشف C. sphaerospermum در منطقهی ممنوعهی چرنوبیل توجه مجددی را به قارچهای رادیوتروف به ویژه به دلیل نقش بالقوهشان در پاکسازی زیستی جلب کرده است (فرآیند استفاده از موجودات زنده برای حذف آلایندهها از محیط زیست).
بر اساس مقالهای که آوریل ۲۰۰۸ در FEMS Microbiology Letters منتشر شد، در محوطههای رادیواکتیو مانند چرنوبیل، جایی که روشهای پاکسازی معمولی چالشبرانگیز و خطرناک است، قارچهای رادیوتروفیک میتوانند جایگزین طبیعی و ایمنتری باشند. از آنجا که C. sphaerospermum میتواند تشعشعات را جذب کند و به عنوان سوخت از آنها استفاده کند، دانشمندان در حال بررسی امکان گسترش این قارچها برای مهار و کاهش بالقوه سطوح تشعشعات در مناطق آلوده هستند.
فرای مرزهای این منطقهی ممنوعه، دانشمندان در حال بررسی کاربردهای دیگر این قارچ، به ویژه در زمینهی اکتشافات فضایی هستند. محیط خشن و پرتشعشع فضا یکی از مهمترین چالشهای پیش روی مأموریتهای طولانی به مریخ و فراتر از آن است.
C. sphaerospermum قبلاً برای آزمایشاتی به ایستگاه فضایی بینالمللی (ISS) فرستاده شد تا روشن شود آیا تحمل تشعشع خاص آن میتواند از فضانوردان در برابر تشعشعات کیهانی محافظت کند یا نه. نتایج اولیه امیدوارکننده بود و نشان داد که میتوان از این قارچ به طور بالقوه برای ایجاد زیستگاههای مقاوم در برابر تشعشع یا حتی تهیهی منابع غذایی محافظتشده در برابر تشعشع برای مسافران فضایی استفاده کرد.
قدرت سازگاری برای هدایت نوآوری
C. sphaerospermum جدای عادات غذایی خاص خود، به سرسختی هم مشهور است. این قارچ میتواند دمای پایین، غلظت بالای نمک و اسیدیته شدید را هم تحمل کند، از این رو به یکی از مقاومترین قارچها تبدیل شده است. توانایی این قارچ برای سازگاری با محیطهای متخاصم، محققان را امیدوار کرده که شاید سرنخهایی برای مطالعات بیشتر درباره مکانیسمهای تحمل استرس داشته باشد. برای نمونه در بیوتکنولوژی و کشاورزی، ژنهای مسئول این سرسختی و انعطافپذیری ممکن است روزی برای تولید مواد مقاوم در برابر تشعشع استفاده شوند یا برای کمک به زنده ماندن محصولات در آبوهوای سخت سازگار شوند.
C. sphaerospermum برای رسیدگی به برخی چالشهای محیطی ضروری هم امید ایجاد کرده: آیا این قارچ میتواند نقشی در پاکسازی زبالههای رادیواکتیو داشته باشد؟
با ادامهی تحقیقات، درسهایی که از این قارچ شگفتآور میآموزیم، الهامبخش این فکر خواهند بود که طبیعت چگونه همیشه با دنیای اطراف و مرزهای زندگی و آنچه قبلاً غیرممکن تصور میکردیم سازگار میشود.
آخرین اخبار جهان را از طریق این لینک پیگیری کنید.